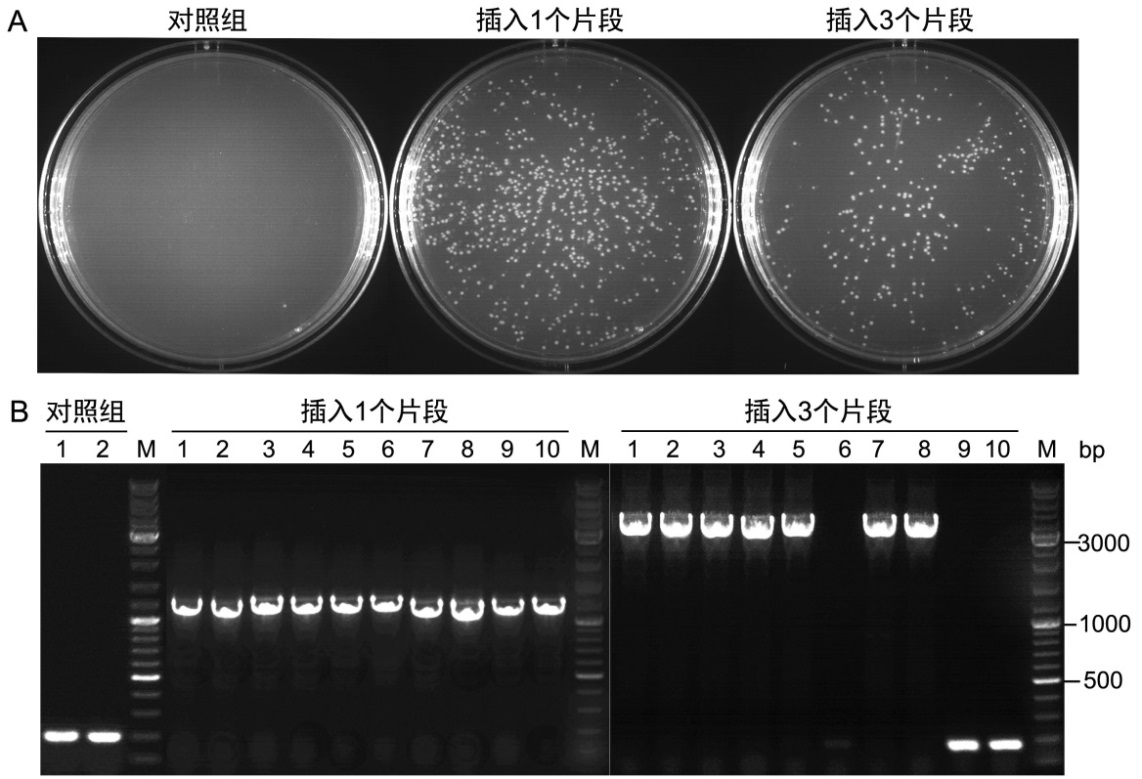
产品细节图片2

相关产品推荐更多 >
万千商家帮你免费找货
0 人在求购买到急需产品
- 详细信息
- 询价记录
- 文献和实验
- 技术资料
- 规格:
20次/100次
| 规格: | 20次 | 产品价格: | ¥341.0 |
|---|---|---|---|
| 规格: | 100次 | 产品价格: | ¥1260.0 |
碧云天生产的Seamless Cloning Kit(无缝克隆试剂盒)是一种新型的基于插入片段和线性化载体的末端进行同源重组的基因克隆试剂盒。本试剂盒利用包含了DNA 5' 外切酶(5' Exonuclease)、DNA聚合酶(DNA Polymerase)和DNA连接酶(DNA
Ligase)活性的重组酶(assembly enzyme),通过同源重组的方法可以将一个或多个DNA片段按照预定方向、快速、高效和精确
地插入到线性化载体中,并且最终构建的克隆没有任何额外的碱基序列,因此被称作“无缝克隆”。
和传统的基因克隆方法相比,本试剂盒的无缝克隆方法有多方面的突出优点:(1) 最终构建的克隆没有任何额外的碱基序列,因此是真正的"无缝克隆";(2) 可通过一个反应将一个或多个片段快速、定向地插入到载体的任何位置;(3) 待插入的PCR扩增产物无须酶切;(4) 插入片段的大小范围宽,从20bp左右的小片段到10kb左右的大片段都可以成功插入;(5) 可通过PCR扩增获得线性化载体,因此限制性内切酶消化并不是克隆所必须的;(6) 酶催化的重组连接反应非常快速和高效,对于一个片段的插入仅需50℃处理15分钟;对于三个片段的插入仅需50℃处理30分钟,而对于5个片段的插入也仅需50℃处理约60分钟;(7) 只有插入片段和线性化载体的末端才能发生同源重组,可以有效避免非特异性的同源重组;(8) 阳性克隆比例高,单个DNA片段克隆的阳性率几乎为100%,三个片段的克隆阳性率约为70-80%。
本无缝克隆试剂盒操作非常简单。本试剂盒进行基因克隆时没有酶切位点的限制,仅需在载体的预定克隆位点通过酶切进行线性化或通过PCR的方法直接制备线性化的载体,在插入片段的两个PCR引物的5' 端引入与载体克隆位点两端完全一致的
15~25bp的重叠序列。重组反应可以在50℃快速进行,3-4小时内即可完成从DNA样品的PCR扩增、纯化、重组、到转化涂板的全部操作。其中PCR反应约2-3小时,PCR产物纯化约20分钟,重组反应15分钟,转化涂板约40分钟,共计约3-4小时即可完成。
碧云天无缝克隆试剂盒的工作原理示意图请参考图1。

图1. 碧云天无缝克隆试剂盒的工作原理图。重叠区域(overlap region)的DNA序列完全一致,通常长度为15-25bp。不同颜
色的重叠区域代表不同的重叠序列。在插入2个或以上片段时,不同的重叠序列可以确保待插入片段有序地插入到线性化的载体(linearized vector)中。
本试剂盒中提供的linearized pUC18为通过EcoRI和BamHI双酶切制备。为检测本试剂盒的连接效率,试剂盒还提供了一个1100bp的DNA fragment, 通过使用pUC18的通用测序引物(M13 forward sequencing primer (5´-GTAAAACGACGGCCAGT-3´)和M13 reverse sequencing primer (5´-CAGGAAACAGCTATGAC-3´))可对连接转化后的克隆进行菌落PCR扩增,扩增后得到1300bp的片段的克隆则为阳性克隆,而扩增后得到200bp的片段的克隆则为阴性克隆。
本试剂盒用于一个1100bp片段的克隆和三个不同的1100bp片段的克隆,其重组反应产物转化DH5α感受态细胞后涂板获得的LB平板的实测效果参考图2A,菌落PCR鉴定结果参考图2B。
图2. 本试剂盒用于无缝克隆的实测效果。A. 本试剂盒反应产物转化感受态细菌DH5α后涂板获得的LB平板效果图。在20μl反应体系中,将EcoRI和BamHI双酶切线性化的载体pUC18 (Linearized pUC18),与通过PCR扩增的含有重叠序列的插入片段(DNA fragment, 1100bp)混合(pUC18载体与PCR片段的摩尔比为1:3);或者与3个有适当重叠序列的不同的1100bp片段混合,pUC18载体与PCR片段的摩尔比为1:1:1:1,然后加入10μl的2X Seamless Cloning Mix,并用水补至20μl,50℃反应15min(插入一个片段)或30min(插入三个片段)。反应结束后,将反应产物放置在冰上5min,取5μl转化到100μl的DH5α感受态细菌中。对照组中只加入线性化的载体pUC18,同时也在50℃反应15min。实验结果表明,插入片段数目越多转化后得到的克隆数越少。B.菌落PCR鉴定用本试剂盒构建得到的克隆。实验结果表明,插入1个片段时的阳性率基本上为100%,插入3个片段时的阳性率约为70%左右。菌落PCR使用的是pUC18的通用测序引物M13 forward sequencing primer (5´-GTAAAACGACGGCCAGT-3´)和M13 reverse sequencing primer (5´-CAGGAAACAGCTATGAC-3´)。
包装清单:
| 产品编号 | 产品名称 | 包装 |
| D7010S-1 | 2X Seamless Cloning Mix | 200μl |
| D7010S-2 | Linearized pUC18 (25ng/μl) | 6μl |
| D7010S-3 | DNA fragment (1100bp, 30ng/μl) | 6μl |
| D7010S-4 | Nuclease free water | 200μl |
| — | 说明书 | 1份 |
| 产品编号 | 产品名称 | 包装 |
| D7010M-1 | 2X Seamless Cloning Mix | 1ml |
| D7010M-2 | Linearized pUC18 (25ng/μl) | 20μl |
| D7010M-3 | DNA fragment (1100bp, 30ng/μl) | 20μl |
| D7010M-4 | Nuclease free water | 1ml |
| — | 说明书 | 1份 |
保存条件:
-20℃保存,一年有效。
注意事项:
单个片段的PCR产物进行重组反应时,如果PCR条带单一,可以无须纯化并直接进行重组反应,但PCR产物的体积不得超过重组反应体系的20%,并且重组效率通常会低于纯化后的PCR产物。
对于多个片段的重组反应,重组效率通常会低于单个片段的重组效率,建议胶回收纯化后再进行重组反应。对于3个以上片段的重组反应或重组片段大于5kb时,强烈建议在胶回收后再进行重组反应。通常胶回收后,重组效率可提高2-10倍。
单片段和线性化载体重组时,摩尔比至少为2:1。多片段和线性化载体重组时,各个片段和线性化载体的摩尔数宜保持一致。
本产品仅限于专业人员的科学研究用,不得用于临床诊断或治疗,不得用于食品或药品,不得存放于普通住宅内。
为了您的安全和健康,请穿实验服并戴一次性手套操作。
风险提示:丁香通仅作为第三方平台,为商家信息发布提供平台空间。用户咨询产品时请注意保护个人信息及财产安全,合理判断,谨慎选购商品,商家和用户对交易行为负责。对于医疗器械类产品,请先查证核实企业经营资质和医疗器械产品注册证情况。
- 作者
- 内容
- 询问日期
文献和实验Seamless Ligation Cloning Extract (SLiCE) Cloning Method
. SLiCE overcomes the sequence limitations of traditional cloning methods, facilitates seamless cloning by recombining short end homologies (15–52 bp) with or without flanking heterologous sequences and provides an effective strategy for directional
BioBrick Assembly Using the In-Fusion PCR Cloning Kit
™ assembly normally involves assembly of two BioBricks™ at a time using restriction enzymes and DNA ligase. Here we describe an alternative BioBrick™ assembly protocol that describes the assembly of two BioBricks™ using the In-Fusion PCR Cloning Kit
Nature of the InsertThe cloning of PCR-amplified fragments into a linear vector is typically a rapid and efficient process. However, not all PCR fragments will clone with the same efficiency into the same vector. These differences
技术资料暂无技术资料 索取技术资料











